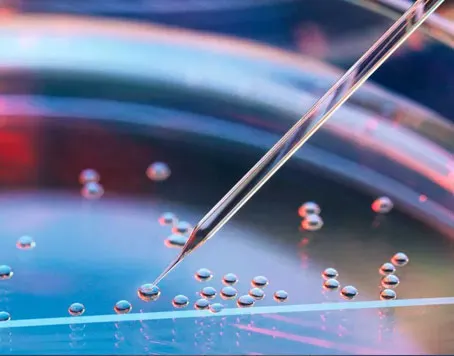

Stem cells, on the other hand, are cells that have yet to be assigned a particular function and can transform into almost any cell that is needed. Throughout a person's life, stem cells exist in their body. These stem cells can be used by the body at any time. Adult stem cells, also known as tissue-specific or somatic stem cells, occur in the body from the time an embryo grows.
Adult body tissues and embryos are the two primary sources of stem cells. Using genetic "reprogramming" methods, scientists are also working on ways to construct stem cells from other cells which we called Induced Pluripotent Stem Cells (IPSCs)
Stem cells do not serve a single purpose, but they are valuable for a variety of reasons. First, under the right conditions, many stem cells can take on the role of any type of cell with the right stimulus, and they can regenerate damaged tissue. This capability may save lives or help people heal wounds and tissue damage after an illness or injury. Stem cells have a wide range of therapy, according to scientists.
Regeneration of Tissues-
The most common application of stem cells is for tissue regeneration such as muscles in muscular dystrophy and other cardiac MI related cases, cartilage in joints, almost all type of eye, kidney, brain, lung, heart and even almost all tissue and blood specific cells in human body.
Treatment for cardiovascular disease-
Within two weeks of the stem cells being implanted, networks of blood vessels had emerged. These new blood vessels were of the same high quality as the natural ones in the area.
To get most of the specialized stem cell treatment in Bangladesh, stem cell cure center is a spot to visit. Their promise is shown by the use of blood stem cells to cure blood cancers, a stem cell treatment that has saved thousands of lives. We have experimental stem cell therapy, where all other medical treatments have failed and stem cell treatment is used to treat so many degenerative diseases that are now incurable.
